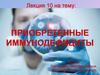
Приобретенные иммунодефициты

Similar presentations:
Приобретенные (вторичные) иммунодефициты
1. Государственное бюджетное образовательное учреждение высшего профессионального образования «ПЕРВЫЙ САНКТ-ПЕТЕРБУРГСКИЙ
ГОСУДАРСТВЕННЫЙМЕДИЦИНСКИЙ
УНИВЕРСИТЕТ ИМЕНИ АКАДЕМИКА И.П. ПАВЛОВА»
МИНИСТЕРСТВА ЗДРАВООХРАНЕНИЯ РОССИЙСКОЙ
ФЕДЕРАЦИИ
Кафедра
иммунологии
2. «Приобретенные (вторичные) иммунодефициты»
Практическое занятие № 4«Клиническая иммунология»
3. Контроль исходного уровня знаний: фронтальный опрос
1.Дайте определение понятию «вторичная иммунологическая недостаточность».2.Назовите основные причины ВИД.
3.Что такое «физиологическая» ВИД?
4.Назовите основные показатели клеточного и гуморального звена врожденного
иммунитета, оцениваемые в иммунограмме.
5.Назовите основные показатели Т клеточного звена, оцениваемые в
иммунограмме.
6.Назовите основные показатели В клеточного звена, оцениваемые в
иммунограмме.
7.Какие клетки и гуморальные факторы участвуют в защите против
внеклеточных бактерий?
8.Какие клетки и гуморальные факторы участвуют в защите против
внеклеточных и какие - против внутриклеточных бактерий?
9.Какие клетки и гуморальные факторы участвуют в защите против вирусов?
10.Какие клетки и гуморальные факторы участвуют в противоопухолевой
защите?
4. Последствия дисрегуляции иммунного ответа
Недостаточностьконтроля
аутоиммунных
реакций
Недостаточность
иммунного
ответа
Иммунодефициты
Аутоиммунные
заболевания
Недостаточность
контроля
пролиферации
лимфоцитов
Злокачественные
лимфопролифера
тивные
заболевания
5. ВИД – это не нозологическая форма
ВИД - это клинико- патогенетическаяхарактеристика транзиторных (в большинстве
случаев) нарушений иммунной системы как у детей,
таки у взрослых, не связанных с генетическими
дефектами иммунной системы.
Следует помнить, что:
транзиторные изменения параметров иммунной
системы возможны у практически здоровых лиц,
их выявление не всегда свидетельствует о наличии
ВИД.
6. Основные признаки развития ВИД
1.2.
3.
4.
5.
6.
Отсутствие генетического дефекта развития иммунной системы.
Возникновение ИД на фоне ранее нормально функционировавшей
иммунной системы.
Устойчивое сохранение возникших нарушений иммунной системы
после устранения причины.
Наличие некоторых клинических проявлений ИД у больного в виде
очагов хронической инфекции в разных органах и системах.
В иммунограмме изменения показателей адаптивного и врожденного
иммунитета носят не постоянный характер, одновременно
отмечаются в разных звеньях иммунной системы.
Возможность достижения клинико-иммунологического эффекта при
проведении адекватной терапии или спонтанное выздоровление.
7. Иммунодефицитные состояния
Дефекты иммунной системы могут быть следствием генетических поломок(первичные иммунодефициты-ПИД).
или результатом воздействия на иммунную систему внешних факторов
(вторичные иммунодефициты-ВИД).
Различают также так называемые «физиологические» ИД .
Они проявляются на определенном этапе жизненного цикла человека и связаны с
объективными причинами:
Возраст:
• Ранний детский.
• Подростковый.
• Старческий.
Беременность.
8. Иммунологический анамнез
Иммунологический анамнез отличается от другихвидов анамнеза своими целями и задачами.
Целью иммунологического анамнеза является
• попытка установить наличие нарушений
иммунной системы у конкретного больного.
• выявить – врождённый или приобретённый
характер этих нарушений.
• дать ориентировочную оценку нарушений в
отдельных звеньях иммунной системы.
9. Сбор иммунологического анамнеза:
НЕ ОБУСЛОВЛЕНЫГЕНЕТИЧЕСКИМИ
ДЕФЕКТАМИ
ФИЗИОЛОГИЧЕС
КИЕ:
1. ВОЗРАСТНЫЕ:
Ранний детский.
Подростковый.
Старческий.
2. БЕРЕМЕН
НОСТЬ
ИД
ВТОРИЧНЫЕ –то есть
развиваются вследствие
каких-либо причин:
- Neo лимфоидной ткани.
- Инфекции (вирусы –
например ВИЧ).
- Нарушение питания.
- Лечение основного
заболевания
иммунодепрессантами и
т.д.
ОБУСЛОВЛЕНЫ
ГЕНЕТИЧЕСКИМИ
ДЕФЕКТАМИ то есть
ПЕРВИЧНЫЕ (ПИД)
ВЫЯВЛЕНИЕ
ГЕНЕТИЧЕСКИХ
ДЕФЕКТОВ :
- Нарушение активности
или отсутствие
ферментов.
- Отсутствие каких-либо
популяций клеток
иммунной системы.
- Ослабление
активности клеток
иммунной системы.
10. Задачи иммунологического анамнеза
1. Выявление возможной причины (либо несколькихпричин) развития ИД.
2. Установление времени возникновения ИД.
3. Сбор данных о перенесенных ранее заболеваниях и их
анализ с позиции «болезней-масок», что дает
возможность предположить нарушения в том или ином
звене иммунной системы.
4. Анализ семейного анамнеза и выяснение
иммунопатологии у родственников (злокачественные,
аутоиммунные, аллергические, хронические гнойновоспалительные и иные заболевания).
5. Оценка эффективности ранее применявшейся
иммунотерапии.
11. «Болезни-маски» ВИД при нарушениях гуморального иммунитета
1. Генерализованные бактериальные инфекции (сепсис,менингит).
2. Рецидивирующие и хронические бактериальные
инфекции ЛОР-органов (синуситы, отиты).
3. Повторные бактериальные поражения органов дыхания:
пневмонии, плевриты, бронхоэктатическая болезнь.
4. Хронические бактериальные инфекции кожи и
подкожной клетчатки (фурункулы, абсцессы, пиодермии,
флегмоны, парапроктиты и т.д.).
5. Другие хронические бактериальные очаги органов и
систем (мочевыделительная, желудочно-кишечная и др.).
12. «Болезни-маски» ВИД при нарушениях преимущественно Т –клеточного звена иммунитета
1. Грибковые заболевания кожи, слизистых оболочек, в томчисле системные формы (кандидозы, аспергиллезы).
2. Паразитарные инвазии.
3. Хронические вирусные инфекции (герпес, ЦМВ, ВЭБ).
4. Туберкулез.
5. Аутоиммунные заболевания.
6. Онкопатология, лимфопролиферативные заболевания.
7. Частые ОРВИ (более 6 раз в год).
13. «Болезни-маски» ВИД при нарушениях фагоцитарного звена (врожденный иммунитет)
1. Фурункулы, карбункулы, абсцессы.2. Повторные ангины, фарингиты, тонзиллиты
3. Другие хронические локализованные очаги
поражения (хронический пиелонефрит,
аднексит, гайморит, отит и др.).
14. Перечень возможных причин ВИД
1.2.
3.
4.
5.
6.
7.
Заболевания –онкологические, аутоиммунные, инфекционные (в том
числе ВИЧ-инфекция).
Травмы, ожоги, операции, наркоз.
Внешние факторы – ионизирующая радиация, токсические вещества,
в том числе алкоголь, ядохимикаты.
Лекарственные препараты - цитостатики, глюкокортикоиды.
Нарушение питания- белково-энергетическая неполноценность
питания, дефицит витаминов, микроэлементов (цинка. Селена и др.).
Вредные факторы производственной среды.
Стресс.
15. Важнейшие факторы, оказывающие влияние на иммунную систему
ПитаниеЛекарства
Хронические
заболевания
Стресс
Иммунная
система
Травмы,
операции
Экологическая
обстановка
Психика
Наркотики, в том числе
никотин и алкоголь
16. Сбалансированное питание (белки) + состояние слизистой ЖКТ
17. Наиболее распространённые причины вторичных иммунодефицитов у пожилых, усиливающие их физиологический иммунодефицит
Старение иммунной системы (перерождение тимуса, снижение активности Т-лимфоцитов)- физиологический иммунодефицит пожилых.
Старение организма в целом (замедление обмена веществ).
Перенесенные инфекции (вирус Эпштейн-Барр и др.).
Возрастные изменения в работе гормональной и центральной нервной систем.
Нарушение работы ЖКТ.
Стрессы.
Психические расстройства.
Несбалансированное питание.
Авитаминозы.
Полиморбидность.
Результаты лечения различных хронических заболеваний.
Опухоли /химиотерапия/.
18. Иммунная система новорожденных: физиологический иммунодефицит врожденного иммунитета
Показатели повышены:Показатели снижены:
(по сравнению со взрослыми)
Снижен уровень компонентов системы
комплемента (С3)
Снижены уровни IgM
Физиологическая незрелость лейкоцитов
новорожденных :
- снижен хемотаксис нейтрофилов
- снижена поглотительная способность фагоцитов
- снижены уровни опсонинов по отношению к
различным бактериям, что обусловлено
сниженным уровнем С3, и сниженным уровнем
IgM .
Бактерицидная активность
лейкоцитов новорожденных к
различным микроорганизмам по
сравнению с таковой у лейкоцитов
взрослых является нормальной или
даже повышенной.
Повышен лизоцим сыворотки.
19. Уровни иммуноглобулинов у новорожденных
Особенности иммунитета новорожденных1. Внутриутробно ребенок не сталкивается с микроорганизмами, собственная иммунная
система у него неактивна.
2. Дефицит IgM антител в период гестации.
3. Во время беременности от матери к ребенку попадают только Ig класса G.
4. Приобретенные от матери Ig в крови ребёнка сохраняются около 6 месяцев.
5. Недостаточная способность к фагоцитозу.
6. Низкая продукция интерферонов.
Формирование иммунной системы у ребенка заканчивается только к 7
годам
19
20. Динамика материнских и собственных иммуноглобулинов у плода и у новорожденного
Рис21. 1 критический период - период новорожденности (первые 4 недели)
1.2.
3.
4.
5.
6.
7.
8.
Лимфоцитоз с 5 суток.
Количество клеток не сопровождается адекватной функцией.
Гуморальная защита за счет материнских антител.
Низкая чувствительность к действию цитокинов- снижена
экспрессия рецепторов к цитокинам.
Слабая противовирусная защита.
Снижена экспрессия костимулирующих молекул (CD40-CD40L ,
CD28-CD28L).
Недостаточные реакции активации комплемента.
Снижена фагоцитарная активность клеток.
22. Иммунная система детей раннего возраста: факторы, не способствующие преодолению физиологического иммунодефицита
«Экзогенные» факторы:• Неблагоприятная экология.
• Раннее начало посещения
детских дошкольных
учреждений (инфекции).
• Низкий уровень образования,
санитарной культуры,
неблагоприятные социальнобытовые условия.
• Недостаточно
сбалансированное питание.
• Гипо- и авитаминозы.
• Психоэмоциональные стрессы.
• Назначение необоснованной
антибактериальной терапии.
«Эдогенные» факторы
• Определенная «незрелость»
внутренних органов и иммунной
системы.
• Очаги хронической инфекции в
ЛОР-органах.
• Дисбактериоз кишечника.
• Изменения функции желез
внутренней секреции.
• Наличие аллергических
заболеваний.
23. Вакцинация – как метод минимизации проявлений физиологического ВИД у детей и у пожилых
ПоказателиСлучаи госпитализации
среди пожилых
Снижение
показателя
на 48%
Смертность среди пожилых
на 50–68%
Случаи заболевания
гриппом среди привитых
здоровых людей
младше 65 лет
на 70–90%
Случаи заболевания
гриппом среди привитых
детей
Острый отит среди детей
на 60–90%
на 30–36%
Вакцинопрофилактика
В вакцинации против различных
инфекций, в первую очередь,
нуждаются, группы риска
заболевания, развития осложнений
• дети раннего, дошкольного и
школьного возраста,
• медицинские работники,
• возраст старше 60 лет,
• воинский контингент,
• работники транспорта,
• лица, страдающие
хроническими соматическими
заболеваниями.
Источник: НИ гриппа Миинздравсоцразвития
www.influenza.spb.ru
24.
Применениеиммуномодуляторов
В составе
комплексного лечения
• Острые и хронические воспалительные
заболеваний любой этиологии (в том
числе ОРВИ, грипп).
• Септические состояния.
• Гнойные хирургические инфекции.
• Хронические рецидивирующие
урогенитальные инфекции.
• Заболевания респираторного тракта.
• Туберкулез.
• Онкологические заболевания
(сопутствующая терапия).
В виде монотерапии
• Восстановление иммунитета после
перенесенных «истощающих»
заболеваний.
• Профилактика инфекций и
восстановление иммунитета
(онкологическихе больные).
• Перед началом осенне-зимнего сезона
для
профилактики обострений
воспалительных
заболеваний у ЧДБ (часто и длительно
болеющих лиц)
25. Физиологический иммунодефицит при беременности
Материнская иммунная системадолжна обладать способностью к
формированию баланса:
• С одной стороны, обеспечивать
защиту организма беременной и
плода от патогенных
микроорганизмов,
• С другой стороны, обеспечивать
иммунологическую толерантность
к аллоантигенам отца для
успешного развития плода на всем
протяжении беременности
Гармоничное развитие
беременности становится возможным
только в условиях компромисса
между иммунологической защитой
матери и плода от инфекционных
агентов и иммунологической защиты
плода от агрессии ИС матери –
развитие «иммунологической
привилегированности матки» во
время беременности, которая
возникает в результате тонкого
взаимодействия клеточных,
гуморальных, пара- и аутокринных
факторов на уровне плаценты.
26. Антигены плода при беременности –иммунная система матери должна находиться в состоянии ИД
• Антигены EVT интерстициального трофобласта:- Антигены МНС-I классические HLA-C (вызывают иммунный
ответ клеточный и гуморальный-АТ).
- Антигены МНС-I неклассические HLA-E, HLA-F, HLA-G
(иммуномодулирующее действие).
• MiHA минорные антигены гистосовместимости – обусловлены
полиморфизмом генов нормальных белков (напр. мужской H-Y).
• Эмбриональные антигены (AFP, hCG, TPS, PSA, MCA, CA125,
SCC).
• Антигены спермы.
27. Антигены плода при беременности –иммунная система матери должна находиться в состоянии ИД
• Ворсинки трофобласта омываются кровьюматери.
• Растворимые молекулы MHC, эмбриональные
антигены, дебрис поступают во все и селезенку
материнского организма.
• Экстраворсинчатый интерстициальный
трофобласт контактирует с иммунными клетками
децидуальной оболочки (локальный ответ в зоне
интерфейса).
28. Зоны контактов плода и иммунной системой при гемохориоидальном типе плаценты (Moffett, Loke 2006)
29. Антигены плода при беременности: иммунная система матери должна находиться в состоянии ИД. Каким образом достигается
толерантность к антигенам плода?1. Система факторов, предотвращающих прямые контакты или активацию клеток
иммунной системы:
- Трофобласт покрыт слоем синцитиотрофобласта, который не экспрессирует
аллоантигены.
- В децидуальной оболочке выключен синтез многих хемокинов, привлекающих
воспалительные клетки.
- В децидуальной оболочке мало лимфатических сосудов.
- Дендритный клеток тоже мало и они не мигрируют в лимфоузлы.
2. Создание микроокружения, необходимого для индукции толерантности,
дифференцировки iTregs:
- Эпителий матки и трофобласт синтезируют противовоспалительные цитокины TGFβ и
IL-10, 4, 13.
- IDO индоламин 2,3 дезоксигеназа (трофобласт, мкф, ДК; NK-IFNγ-мкф-IDO) –
индукция Tregs.
- Толерогенные дендритные клетки LILRB1 реагирует с HLA-G.
- Ворсинчатый трофобласт синтезирует гормоны: прогестерон и хорионический
гонадотропин.
30. Подавление адаптивного иммунитета на фоне активации врожденного иммунитета при беременности
Прогестерон,эстрогены, ХГ,
плацентарный
лактоген и др.
Локальные медиаторы
действия стероидов ростовые факторы и
цитокины
Плацента
Врожденный
иммунитет
Активация фагоцитоза.
Угнетение апоптоза
фагоцитов.
Угнетение выработки
провоспалительных
цитокинов.
Усиление продукции ИФНв,
NO.
Адаптивный
иммунитет
Инволюция тимуса.
Угнетение пролиферации Т
лимфоцитов.
Формирования Тh2фенотипа
Увеличение числа Т-reg
(CD4+CD25+Fox P3+).
31.
Физиологическаябеременность
Th2
Невынашивание
Стимуляция иммунной системы матери антигенами
трофобласта предполагает наличие механизмов,
ограничивающих адаптивный иммунный ответ,
обеспечивающих защиту зародыша:
«механизм цитокинового сдвига»:
после оплодотворения в иммунной системе происходит
устойчивое смещение равновесия Th1/Th2 в сторону
Th2.
Th1
IL4
IL5
TGF
b
IL10
IL2
IL18
IL6
IL12
IFNγ
Th1
Th2
IL4
IL5
TGF
b
IL10
IL2
IL18
IL6
IL12
IFNγ
32. Классификация ВИД: - индуцированная форма, - спонтанная форма, - СПИД
Индуцированная форма ВИД развивается в результате:1. Действия конкретных групп причин (ионизирующее
излучение, применение цитостатиков, кортикостероидов,
при травмах, хирургических вмешательствах, стрессах,
нарушениях питания и т.д.)
2. Вторично по отношению к основному заболеванию
(онкопатология, сахарный диабет, заболевания печени,
почек, инфекции и т.д.)
33. Классификация ВИД: - индуцированная форма, - спонтанная форма, - СПИД
Спонтанная форма ВИД:1. Характеризуется отсутствием явной причины,
вызывающей нарушения в иммунной системе.
2. Клинически проявляется в виде хронических часто
рецидивирующих инфекционно-воспалительных
заболеваний органов дыхания, ЖКТ, урогенитального
тракта, вызванных условно-патогенной флорой.
3. Хронические заболевания трудно поддаются
традиционному лечению.
34. Иммунодиагностика при подозрении на ИД
1. Применение инструментальных методов (компьютернаяи рентгенодиагностика, УЗИ и т.д.) позволит
диагностировать изменение размеров тимуса,
спленомегалию, охарактеризовать лимфоузлы и т.д.
2. Иммунологичсекие тесты назначает врач аллергологиммунолог учетом предполагаемых дефектов в
иммунной системе .
3. При необходимости врач аллерголог-иммунолог
назначает проведение повторных иммунологических
исследований на фоне или после проведенного лечения
(иммунологический мониторинг).
35. ВИД : клинические и лабораторные критерии
Клинические критерииЛабораторные критерии
Частые обострения вялотекущих
хронических воспалительных
заболеваний
Частые ОРВИ (более 5-6 раз в год)
↓ Содержания форменных элементов
крови в гемограмме
Частые обострения герпесвирусной инфекции
↓ Число общего числа Т-лимфоцитов;
популяций и субпопуляций
Длительный субфебрилитет
↓ Функциональной активности
фагоцитов, системы комплемента
Лимфоаденопатия
Нарушения продукции интерферонов,
дисбаланс синтеза цитокинов Th1- и
Th2-клетками
Изменения состояния спонтанного и
индуцированного апоптоза,
↓ аффинности антител
Отсутствие достаточного
клинического эффекта после
назначения стандартной терапии
по поводу имеющегося у пациента
заболевания
↓ Уровни IgA, IgM, IgG в крови
36.
Инфекции и иммунитетoesophagus
Candida
Нормальные миндалины Нормальная кожа
Стрептококковая
инфекция
Стафилококковая
инфекция
37. Варианты иммунного ответа на бактериальную инфекцию
НОРМАЛЬНЫЙ ОТВЕТ«патологический ответ»
• Лейкоцитоз
Чрезмерная
реакция
иммунной
системы
Гиперреактивность
("SIRS"-ответ),
• Относительная лимфопения
•Повышение функциональной
активности фагоцитов,
выявляемое по образованию
активных форм кислорода
•повышение уровня
Ig всех классов А,М,G,E
•Повышение уровня
маркеров воспаления:
ФНО, ИЛ-8, СРБ, ПКТ, ИЛ-2,
ИЛ-1, ИЛ-1β, ЦИК, комплемента
•Повышение пролиферативной
активности Т-лимфоцитов
Недостаточный
ответ
иммунной
системы
Гипореактивность
("CARS"-ответ).
(Булава Г.В.)
Утяжеление течения инфекционного
процесса
38.
Иммунологические показатели у более 10000 больных с бактериальной инфекцией1. В 71- 90 % случаев выявлены нарушения фагоцитарного звена:
•74% - снижение фагоцитарного индекса.
•82% - снижение внутриклеточной бактерицидности нейтрофилов.
•58 - 90% снижение индуцированной и спонтанной хемилюминесценции.
2. В 63,6% случаев выявлены нарушения гуморального звена:
•30,6% - дисиммуноглобулинемии.
•42 % - снижение уровня IgG.
•43,8% - снижение аффинности антител.
3. В 43% случаев выявлены нарушения клеточного звена:
•43% - лейкопения.
•48% - снижение CD8+ и CD4+ -лимфоцитов;
•36% -снижение СD 19 + (В лимфоцитов).
4. В 38% случаев - смешанная патология (бактериально - вирусные ассоциации).
5. В 19% случаев - изменений иммунологических параметров не выявлено.
39. ЧБД (часто длительно болеющие): принципы лечения ОРВИ
Патогенетический подход.
Комплексность терапии.
Профилактика (закаливание, физические упражнения, витамины,
вакцинация, консультация невролога и психолога и др.).
Физиотерапия (УФО, массаж и др.).
Санация очагов хронической инфекции (заболеваний органов ЖКТ,
лечение паразитарных инвазий и др.).
Фармакотерапия (симптоматическая терапия ОРВИ
(противовирусные препараты, отхаркивающие средства и т.д.).
Лечение сопутствующих заболеваний.
По показаниям-иммунотерапия).
40.
Заместительная иммунотерапия: применениеиммуноглобулинов в клинической практике
Препараты
иммуноглобулинов
Профилактика
Лечение
Иммуномодулирующая
терапия
Специфические Ig:
•Перед контактом с инфекцией.
•В зоне эпидемии.
Острые ситуации
Заместительная терапия
(восполнение дефицита АТ )
Хронические состояния
41. Механизмы действия заместительной терапии препаратами иммуноглобулинов при сепсисе и тяжелых инфекциях
Высокоаффинные антитела осуществляет быструю
нейтрализацию эндотоксинов, экзотоксинов и
суперантигенов.
Широкий спектр высокоаффинных антител способствует
быстрому комплемент-опосредованному уничтожению
бактерий.
Широкий спектр высокоаффинных антител после
опсонизации бактериальных агентов cпособствует
повышению активности фагоцитов (путем активации их Fc рецепторов).
42. Алгоритм иммуномодулирующей терапии у больных с острыми хирургическими заболеваниями
Иммунный ответ на деструкцию тканей при острыххирургических заболеваниях
Фаза индукции
1-3 сутки
(профилактика)
Развитие вторичной
иммунной
недостаточности
Адекватный
иммунный ответ
Иммунокоррекция
не показана
Иммунокоррекция
показана
1-3 сутки
• иммуноглобулины
•полиоксидоний
Сравнительный анализ эффективности профилактической
иммуномодулирующей терапии у больных с тяжелым острым
панкреатитом.
С 4-х суток
•тимические
•миелопептиды
•полиоксидоний
89%
74%
100%
52%
39%
33%
80%
60%
40%
7%
20%
1 гр.-раннее 2 гр.-позднее 3 гр.-без ИМ
назначение назначение
ИМ
ИМ
гнойные осложнения
летальность
0%
Боровкова Н.В.Вторичный иммунодефицит при гнойно-септических осложнениях
хирургических заболеваний.Автореферат дисс.д.м.н.,Москва-2011, 50 с.
43. Классификация ВИД: - индуцированная форма, - спонтанная форма, - СПИД
СПИД –синдром приобретенного иммунодефицита, которыйразвивается следствие инфицирования вирусом
иммунодефицита человека (ВИЧ)
ВИЧ относится к семейству РНК- содержащих ретровирусов,
имеющих фермент- обратную транскриптазу.
Описаны 2 вида ВИЧ- ВИЧ 1 и ВИЧ 2.
Генетический аппарат ВИЧ-1 и ВИЧ-2 схож между собой по
последовательности нуклеотидов на 50%.
ВИЧ-1 более распространен в США, Европе, России.
Центральной Африке; ВИЧ-2-эндемичен для Западной
Африки.
44. ВИЧ
ВИЧ-1 (открыт в 1983 году Л. Монтанье и Р.Галло); ВИЧ-2 (открыт в 1986 году Л. Монтанье).
Оба типа ВИЧ поражают: Т- лимфоциты, другие
клетки иммунной системы (макрофаги), клетки
нервной системы (в основном головного мозга).
Для ВИЧ характерна высокая степень
изменчивости - в один миллион раз больше, чем у
вируса гриппа.
В Международной базе данных зафиксировано
более 25 тысяч вариантов ВИЧ.
45.
Число взрослых и детей, инфицированных ВИЧ( данные ВОЗ 2010 г.)
Eastern Europe
Western &
Central Europe & Central Asia
840 000
1.5 million
[770 000 – 930 000][1.3 million – 1.7 million]
North America
1.3 million
East Asia
[1.0 million – 1.9 million]
790 000
Middle East & North Africa
Caribbean
200 000
[170 000 – 220 000]
Latin America
1.5 million
[1.2 million – 1.7 million]
[580 000 – 1.1 million]
470 000
[350 000 – 570 000]
South & South-East Asia
4.0 million
Sub-Saharan Africa
[3.6 million – 4.5 million]
[21.6 million – 24.1 million]
Oceania
22.9 million
54 000
[48 000 – 62 000]
Всего: 34.0 млн [31.6 млн – 35.2 млн]
45
46. Пути инфицирования ВИЧ
Вирус обнаруживается во всех биологических жидкостях зараженногочеловека, но в разных титрах.
Самая высокая концентрация –в крови, сперме, вагинальном
отделяемом, грудном молоке.
Минимальное содержание вируса - в слюне , в слезной жидкости.
Пути проникновения вируса:
• Парентеральный.
• Половой.
• Вертикальный (от матери новорожденному).
Вертикальный путь может происходить по одному из трех вариантов:
Трансплацентарный –антенатальный (вероятность заражения 15-25 %).
В родах-интранатальный путь (60-85 %).
Постнатальный-при грудном вскармливании (12-25%).
47. Прогноз заболевания
• У взрослых обычно происходит длительныйпериод между проникновением ВИЧ и развитием
СПИД. Длительность прогрессирования
инфекции до СПИДа у нелеченых взрослых в
среднем составляет 10 лет.
• Вероятность рождения инфицированного ребенка
от матери с ВИЧ –статусом в европейских странах
составляет 25-30%. В Африке -50-60%.
• У детей период от ВИЧ-инфицирования до
состояния СПИД намного меньше, чем у
взрослых.
48. Строение ВИЧ
Нуклеокапсид ВИЧ содержит:• 2 одноцепочечные молекулы РНК,
• связанные с ними белки p 7 и p 9,
• комплекс ферментов (обратная транскриптазу, интегразу. РНК-полимеразу,
протеиназу),
• основной белок нуклеокапсида ВИЧ- p24.
В зрелых вирионах также содержится белок Vpr.
В состав оболочки ВИЧ входят:
Гликопротеины gp 160 (160 кДа), состоящий из надмембранной части –gp120 и
внутримембранной части –gp 41.
Гликопротеин gp 120 способен связываться с молекулами CD 4 и играет
ключевую роль в проникновении вируса в клетку-мишень.
Значительное число молекул gp 120 отрывается от вирусных частиц и попадает в
кровь и в ткани. Этот процесс называется шеддингом (от анг. Shedding –утечка).
ВИЧ 2 имеет мембранные гликопротены gp 140 (gp105 и gp 36 кДа).
49. Строение ВИЧ
50.
Строение ВИЧ (HIV)50
51. Геном ВИЧ
Геном ВИЧ может существовать в двух вариантах :• в виде геномной РНК,
• в виде ДНК, синтезированной на геномной РНК –как на матрице, и в
виде участка ДНК, интегрированного в какую-либо хромосому
клетки-хозяина (провирусная форма).
В геноме ВИЧ выделяют три группы генов:
• Env –кодируют антигены оболочки вируса,
• Gag –кодируют антигены сердцевины (p 17, p 24, p7).
• Pol- кодируют гены ферментов.
Кроме того, ВИЧ-1 имеет 8 регуляторных генов, ВИЧ -2 -9.
Как и все реторвирусы, ВИЧ обладает сильной изменчивостью и
существует в виде множества квазивидов: ни один дочерний вирион не
воспроизводит родительский в точности – эволюционно отобранный
способ ускользания вирусов от иммунного надзора организма-хозяина.
52. Геном ВИЧ-1
53. Свойства ВИЧ
• Характерная для ВИЧ непрерывная антигеннаяизменчивость позволяет вирусу легко проникать в
клетки хозяина.
• ВИЧ заселяет лимфоциты и клетки миелоидного
ряда.
• Т лимфоциты –хелперы и макрофаги –депо
вируса, так как гликопротеин gp 120 связывается
с молекулой CD4 и рецепторами для хемокинов –
CCR3 и CCR5.
54. Этапы развития ВИЧ -инфекции
• Сначала ВИЧ-1 инфицирует ДК имакрофаги, затем - Т лимфоциты.
Внутриэпителиальные ДК:
• интернализируют вирусы.
• мигрируют с ними в лимфатические узлы.
• в лимфатических узлах ДК представляют
вирусные антигены Т-лимфоцитам.
55. Этапы развития ВИЧ -инфекции
56. Клетки-мишени для ВИЧ
CD4+ T лимфоциты
ДК
макрофаги
клетки Лангерганса
тимоциты
стволовые клетки
костного мозга
микроглия
эпителиальные клетки
Miller J.C. 2007
56
57. Изменения в иммунной системе при ВИЧ-1-инфицировании:проникновение
Изменения в иммунной системе при ВИЧ-1инфицировании:проникновение• Поверхностный gp 120 связывается с молекулами CD 4.
• После связывание происходит изменение оболочки ВИЧ,
gp 41 взаимодействует с плазматической мембраной
клетки организма-хозяина, в результате которого
внутренние компоненты вируса входят в клетку.
• В качестве корецептора для входа в клетку ВИЧ-1
использует также СCR 5-хемокиновый рецептор,
экспрессируемый мононуклеарами(мутации гена СCR 5
защищают клетки хозяина от входа ВИЧ-1).
• Рецепторы CXCR 4 на Т-лимфоцитах также используются
ВИЧ-1 для входа в клетки.
58. Вход ВИЧ в клетку хозяина
59. Этапы развития ВИЧ -инфекции
60. Изменения в иммунной системе при ВИЧ-1-инфицировании:проникновение в геном
Изменения в иммунной системе при ВИЧ-1инфицировании:проникновение в геном• Вновь образованный геном ВИЧ в виде ДНК,
синтезированной с помощью обратной транскриптазы на
геномной РНК –как на матрице, входит в ядро, и в виде
участка ДНК, интегрированного в какую-либо хромосому
клетки-хозяина, может существовать в форме провируса.
61. Этапы развития ВИЧ -инфекции
62. Изменения в иммунной системе при ВИЧ-1-инфицировании: проникновение в геном и размножение ВИЧ
• Активация Т-клетки приводит к низкому уровнютранскрипции провируса.
• Происходит многократный сплайсинг РНК- транскриптов.
• Происходит синтез и сборка всех необходимых новому
вирусу белков, включая белки оболочки.
• Происходит сборка вновь образованных вирусов внутри
клетки организма-хозяина.
• Выход из пораженной клетки организма-хозяина
дочерних вирусов (с выраженными антигенными
изменениями вследствие мутаций ) и заражение других
клеток.
63. Этапы развития ВИЧ -инфекции
64. Терминология (согласно Eisele , Siliciano, Cell, 2012)
ЛатентностьСостояние непродуктивной инфекции в индивидуальной клетке. Латентно
инфицированные клетки сохраняют способность продуцировать
инфекционные вирусные частицы.
Вирусная репликация
Новый цикл инфекции, характеризующийся тем,
что неинфицированные ранее клетки
инфицируются de novo и производят новые
вирусы.
Резервуары
Популяции инфицированных клеток, которые
обеспечивают наличие способных
к репликации вирусов в пациентах, которые
проходят цикл оптимальной антивирусной
терапии на продолжении лет.
64
65.
Жизненный цикл ВИЧ66. Изменения в иммунной системе при ВИЧ-1-инфицировании
Изменения в иммунной системе при ВИЧ-1инфицированииВИЧ-1 может:
• выступать в качестве суперантигена,
• вызывать апоптоз клеток-мишеней
• ииндуцировать цитотоксическое действие CD8+
лимфоцитов, направленное против CD4+ клеток,
экспрессирующих антигены ВИЧ-1.
При ВИЧ инфекции происходит аномальная активация Влимфоцитов (у больных увеличивается синтез IgG и IgA к
антигенам ВИЧ-1).
ВИЧ вызывает дисфункцию иммунной системы, нарушает
процессы распознавания антигенов, вызывает апоптоз
клеток.
67. Изменения в иммунной системе при ВИЧ-1-инфицировании
Изменения в иммунной системе при ВИЧ-1инфицированииНа более поздних стадиях заболевания дисрегуляция в иммунной
системы усиливается:
• Прогрессивно снижается синтез важнейших цитокинов интерферона гамма, интерлейкинов 2,12,13, и др.
• Мононуклеары, инфицированные ВИЧ-1, продуцируют большие
количества провоспалительных цитокинов.
• Нарушается регуляция всех типов иммунных ответов и ответов
врожденного иммунитета.
• Вследствие разрушения и гибели прогрессивно снижается число
CD4+лимфоцитов.
• Активируется низковирулентная флора, включая оппортунистичекие
микрооргназмы.
68. Этапы формирования СПИД – синдрома приобретенного иммунодефицита
• В 50-60% случаев в течение 2-6 недель после заражениявирусом отмечаются гриппо-подобные симптомы.
• В течение последующих 5-8 лет заболевание может
протекать бессимптомно.
• Далее –в течение 2-3 лет –выраженная симптоматика
(инфекционные процессы), прогрессивно снижается число
CD4+ клеток в крови, запустевают органы иммунитета –
тимус, лимфоузлы.
• Последний год жизни – постоянные инфекции (в среднем
от момента заражения до смерти проходит 10-13 лет).
69. Figure 11-20
70. Клинические проявления иммунодефицита при ВИЧ -инфекции
1 фаза - начало инфекции (первые 2-3 недели) –гриппоподобный синдром:лихорадка, головные боли, генерализованная
лимфоаденопатия, артралгии, воспалительные процессы в
глотке и в гортани, кандидоз слизистой оболочки полости
рта, гепато- и спленомегалия, диарея, конъюктивит,
серозный менингит.
2 фаза –бессимптомная- может длиться 5-10 лет.
3 фаза –персистирующая генерализованная
лимфоаденопатия.
71. 3 фаза –персистирующая генерализованная лимфоаденопатия
Генерализованная лимфоаденопатия :• Увеличиваются в основном шейные, над- и подключичные,
подмышечные, кубитальные лимфатические узлы.
• У ряда больных возникают психопатические и неврологические
расстройства, соответствующие подострой энцефало- и
полинейропатии.
• Нарушается сон, снижается внимание, усиливаются головные боли.
72. СПИД-связанный симптомокомплекс
По мере углубления иммуносупрессии присоединяются вторичные
заболевания:
Оппортунистические инфекции, вызываемые условно- патогенными
микроорганизмами.
Злокачественные новообразования (саркома Капоши, В-клеточная
лимфома и др.).
Больные предъявляют жалобы на слабость, быструю утомляемость,
прогрессивную потерю массы тела (10% и более), субфебрилитет,
потливость, нарушение стула.
Происходит неуклонное снижение интеллекта и памяти. Вплоть до
развития ВИЧ-обусловленной деменции.
Прогрессируют оппортунистические инфекции-часто развивается
пневмоцистная пневмония.
73. Клинические проявления у ВИЧ-инфицированных детей
Персистирующая генерализованная лимфоаденопатия
Гепато- и спленомегалия
Лихорадка
Экзема
Паротит
Отит
Синусит
Анемия
Задержка физического и умственного развития
Мышечная слабость
Персистирующая диарея
Лимфоцитарная интерстициальная пневмония
Токсоплазмоз головного мозга (у детей старше 1 года)
Герпетические поражения кожи и слизистых оболочек
74. Иммунный ответ на ВИЧ
75. Диагностика ВИЧ-инфекции
Осуществляется на основе комплексного подхода ивключает критерии:
• Эпидемиологические.
• Клинические.
• Лабораторные.
76. Критерии диагностики ВИЧ-инфекции: группы эпидемиологического контроля
Наркоманы.
Би- и гомосексуалисты, лица, ведущие беспорядочную половую жизнь
Реципиенты, получающие повторные гемотрансфузии и переливание
компонентов крови.
Некоторые профессиональные группы населения, работающие с
контаминированным материалом.
Дети, рожденные от ВИЧ-инфицированных матерей.
Доноры крови, спермы и других биологических жидкостей и тканей(перед
каждым получением материала).
Беременные при постановке на учет.
77. Клинические критерии диагностики ВИЧ-инфекции
Клинические критерии диагностики ВИЧинфекцииНедавно перенесенное заболевание с гриппо- или мунонуклеозоподобным синдромом.
Лихорадка длительностью более 1 месяца.
Увеличение лимфатических узлов двух или более групп дольше 1 месяца.
Необъяснимое снижение массы тала более, чем на 10%.
Затяжные, не поддающиеся обычному лечению пневмонии.
Затяжные и рецидивирующие гнойно-бактериальные, паразитарные заболевания,
сепсис.
Подострый энцефалит с развитием слабоумия у ранее здоровых лиц.
Ворсистая лейкоплакия на языке.
Рецидивирующие пиодермии.
Хронические воспалительные заболевания половой сферы ц женщин неясной
этиологии.
Признаки ряда заболеваний (саркома Капоши, лимфома мозга, Т-клеточный лейкоз,
туберкулез, гепатиты В и С, Hbe – носительство, анемии различного генеза, кандидоз
пищевода, глубокие микозы, заболевания, передающиеся половым путем.
78. Прогрессирование болезни
7879. Критерии лабораторной диагностики ВИЧ-инфекции
Обязательные маркеры ВИЧ:• Определение анти-ВИЧ антител
• Выявление методом ИФА антител к gp 120, gp 41, gp 120/160 и др.;
• Определение методом иммуноблота антител к двум или более
антигенам ВИЧ.
Дополнительные критерии:
• Определение ВИЧ в лимфоцитах методом ПЦР
• Определение p24-антигена методом ИФА
• Выделение ВИЧ в культуре in vitro
Неспецифические лабораторные тесты:
Уменьшение числа CD4+ лимфоцитов, снижение иммунорегуляторного
индекса CD4+ /CD8+ менее 1, гиппергаммаглобулинемия.
Увеличесни уровня циркулирующих иммунных комплексов
Снижение продукции цитокинов
Лейкопения, лимфопения, тромбоцитопения, анемия.
80. «Диагностическое окно» для определения антител к ВИЧ
• Антитела к ВИЧ у 90-95% зараженных ВИЧ появляются вкрови в течение первых трех месяцев после заражения,
• У 5-9% -через 6 месяцев,
• У 0.5-1% -в более поздние сроки.
• Наиболее ранний срок обнаружения антител к ВИЧ –
через 2 недели после заражения (бывает крайне редко).
81. Лечение ВИЧ-инфекции
Основа лечения - проведение специфической антиретровирусной терапии,направленной на снижение смертности больных, сокращения числа СПИДсвязанных заболеваний, восстановления иммунитета, достижения максимального
снижения репликации вируса.
Основные препараты этой группы –ингибиторы обратной транскриптазы.
ВААРТ-высокоактивная антиретровирусная терапия включает :
Комбивир (зидовудин+ламивудин), Калетра (лопинавир+ритонавир), Тризивир
(абакавир+ламивудин+зидовудин).
Перед назначение терапии проводится психосоциальное консультирование.
Критерии назначения антиретровирусной терапии:
• число CD 4+ клеток в крови менее 350/мкл,
• наличие клинических симптомов, свидетельствующих об иммунодефиците,
• уровень вирусной нагрузи,превышающей100 000 копий/мл.
Дополнительный критерий:
Уменьшение числа лимфоцитов в периферической крови ниже 1000-1200/мкл.
82.
Антиретровирусная терапия больных ВИЧинфекциейАнтиретровирусная терапия направлена на прекращение репликации
(размножения) вируса иммунодефицита человека, являющегося возбудителем
ВИЧ-инфекции
83. ВИЧ-1 вакцинация пока не принесла успехов
8384. Рукописный отчет Э. Дженнера о проведенной им вакцинации
85. Существующие и потенциальные мишени антивирусной терапии
85Abbas & Herbein, 201286. Генная терапия ВИЧ
Основанием нового метода лечения послужилслучай выздоровления американского ВИЧинфицированного пациента после пересадки
костного мозга.
Донор костного мозга был носителем
мутации гена CCR5, которая затрудняет
проникновение вируса иммунодефицита в Тлимфоциты.
87. Дельта-32 CCR5
Мутацию "дельта -32 CCR5" открыли более15 лет назад.
Счастливчики, унаследовавшие мутацию
"дельта-32 CCR5" от обоих родителей гомозигота - являются неуязвимыми для
большинства разновидностей ВИЧ.
88. Генная терапия ВИЧ
В ходе эксперимента, проведенного в США,американские ученые решили отредактировать гены
клеток иммунной системы добровольцев с ВИЧинфекцией.
Для этого исследователи удалили ген CCR5 из Тлимфоцитов, выделенных из крови пациентов.
После этого модифицированные клетки были
размножены в лаборатории, а затем введены в
организм испытуемых.
89. Генная терапия ВИЧ
Трое участников исследования получилиприблизительно по 2,5 миллиарда
модифицированных лимфоцитов, еще трое - в два
раза больше клеток.
Спустя три месяца после процедуры численность
модифицированных клеток существенно
увеличилась в крови 5 из 6 испытуемых.
В результате невосприимчивыми к ВИЧ-инфекции
оказались приблизительно 6 % Т-клеток пациентов.
90. Генная терапия ВИЧ
Теоретически в будущем это может привести кзамедлению развития СПИДа у носителей ВИЧинфекции. Однако предстоит выяснить, как
скажется примененная ими методика удаления гена
CCR5 на функциях модифицированных клеток
(сейчас известно, что врожденное отсутствие этого
гена не влияет на здоровье человека).
91. Стратегии блокирования инфекции ВИЧ с помощью снижения экспрессии CCR5 (Andrea Rubbert, Georg Behrens and Mario Ostrowski,
2011)91
92. Частота встречаемости CCR5- Δ32 аллели в мире (самая высокая – в Европе- 9%)
9293.
Длительный контроль ВИЧ инфекции с помощью трансплантации стволовыхклеток костного мозга донора с мутацией Δ32/Δ32 CCR5
Химиотерапия (x4)
Облучение (x2)
CCR5–
Трансплантация
костного мозга
(X2)
CCR5+
CCR5–
Донор
костного
мозга
ВИЧ-1+
ВИЧ-1–
Hütter. NEJM. 2009; Allers. Blood. 2010
94. Генные подходы к терапии ВИЧ -инфицированных
9495. Примеры генной терапии ВИЧ-инфекции
Barton et al., 201295
96. ВОПРОСЫ
1. Что такое приобретенный иммунодефицит?2. Каковы основные отличия приобретенных ИД от первичных ИД?
3. Охарактеризуйте основные цели и задачи иммунологического
анамнеза.
4. Перечислите «болезни-маски» нарушений адаптивного иммунитета
(гуморального и клеточного) и врожденного иммунитета.
5. Каковы отличия «физиологических» ИД от индуцированных или
спонтанно приобретенных?
6. Каковы основные причины возникновения ВИД?
7. Перечислите клинические и иммунологические признаки ВИД.
8. Чем отличается иммунологический анамнез от других видов
анамнеза?
9. Какие формы ВИД выделяют в настоящее время?
10.Какие инструментальные методы можно использовать при
обследовании органов иммунной системы?
97. Тестовые вопросы
Причины приобретенных (вторичных) иммунодефицитов:1. Ионизирующая радиация.
2. Применение цитостатиков.
3. Стрессы.
4. Операции и наркоз.
5. Белковое голодание.
_________________________________________________________________
К приобретенным (вторичным) иммунодефицитам относятся:
1. Индуцированные иммунодефициты.
2. Спонтанные иммунодефициты.
3. Транзиторная младенческая гипогаммаглобулинемия.
4. Селективный дефицит IgA.
5. СПИД.
98. Тестовые вопросы
Основными признаками вторичных иммунодефицитов являются:1. Отсутствие генетического дефекта развития иммунной системы.
2. Развитие ИД на фоне ранее нормально функционировавшей иммунной системы.
3. Наличие в иммунограмме изменений в нескольких звеньях иммунитета.
4. При мониторинге в иммунограмме изменения являются не транзиторными, а носят
стойкий характер и затрагивают один и тот же показатель.
5. Согласно семейному анамнезу отсутствуют больные с ВИД.
_________________________________________________________________
К «болезням-маскам» ИД с преимущественным поражением гуморального звена относятся:
1. Грибковые поражения кожи и слизистых оболочек.
2. Сепсис.
3. Повторные бактериальные пневмонии.
4. Гнойный менингит.
5. Бактериальные риниты, отиты, синуситы.
99. Тестовые вопросы
К «болезням-маскам» ИД с преимущественным поражением клеточного звена неотносятся:
1. Частые ОРВИ (более 6 раз в год).
2. Грибковые поражения кожи и слизистых оболочек.
3. Хронические вирусные инфекции.
4. Паразитарные инвазии.
5. Частые ангины.
_________________________________________________________
Перечень каких «болезней-масок» позволяет заподозрить у больного ВИД с
преимущественным поражением фагоцитарной активности нейтрофилов:
1. Длительно не заживающие раны
2. Частые ОРВИ.
3. Рецидивирующие фурункулезы.
4. Абсцессы.
5. Пиодермия.
100. Тестовые вопросы
Каковы основные характеристики индуцированной формы ВИД:1. Возникают у клинически здоровых людей и выявляются как случайная находка.
2. Имеет конкретную причину (ренгенооблучение, цитостатики, гормоны, травмы).
3. Выявляется у больных с хроническими заболеваниями.
4. Выявляется у лиц, перенесших операции.
5. Отмечаются иммунологические нарушения в разных звеньях иммунной системы.
_________________________________________________________________
В каких случаях нельзя говорить о «физиологическом иммунодефиците»?
1.
2.
3.
4.
5.
При изменении в иммунограмме у детей в первые месяцы жизни.
У женщин в первом триместре беременности.
У женщин в третьем триместре беременности.
У пациентов в пожилом и старческом возрасте.
У ВИЧ-инфицированных пациентов в бессимптомной стадии.
101. Тестовые вопросы
Какие формы ВИД выделяют в настоящее время?1. Индуцированную.
2. Спонтанную.
3. Физиологическую.
4. СПИД.
5. Генетически обусловленную.
_______________________________________________________________
Основными критериями постановки диагноза ВИД не являются:
1. Данные иммунологического анамнеза.
2. Наличие клинических симптомов (изменение размеров ЛУ, селезенки,тимуса).
3. Наличие хронических бактериальных, вирусных,грибковых инфекций, трудно
поддающихся традиционной терапии.
4. Обязательное наличие гипохромной анемии.
5. Наличие хронической гранулематозной болезни (ХГБ).
102. Ситуационная задача №1
Больной М., 13 лет.В раннем детском возрасте болел редко. После начала учебы в школе
стали беспокоить рецидивирующие отиты, риносинуситы, повторные
ангины, бронхиты. Вирусными инфекциями болел редко. При
физикальном обследовании гипоплазии лимфоузлов не выявлено. При
исследовании иммунограммы показатели CD3+ CD 4+CD8+ - в пределах
возрастной нормы. Выявлены изменения в уровне иммуноглобулинов:
IgA-5, 12 г/л, IgM -1,4 г/л, IgG-4,5г/л.
Вопросы:
1. Можно ли рассматривать клинико-иммунологические данные как
проявления ВИД?
2. Каковы возможные причины ВИД?
3. С какого возраста появились симптомы ВИД?
4. В каком звене иммунной системы имеются нарушения?
5. Перечислите «болезни-маски» ВИД у данного пациента.
103. Ситуационная задача №2
Больной С., 34 года.Поступил в клинику с диагнозом «острая левосторонняя нижнедолевая
пневмония» средней степени тяжести. Из иммунологического анамнеза известно.
Что пациент болеет в среднем 1-2 раза в год. Хронических заболеваний не имеет.
В клинике получал стандартную терапию. Выписан спустя 14 дней с
выздоровлением.
При иммунологическом обследовании:
• в день поступления: ЦИК -10 г/л , IgA-1,5 г/л, IgM -4,5 г/л, IgG-9,3 г/л.
при выписке:
ЦИК -4,5 г/л ,IgA-2,3 г/л, IgM -1,1 г/л, IgG-11,3 г/л.
Вопросы:
1. Имеются ли клинико-иммунологические основания предположить у
пациента ПИД до поступления в стационар?
2. Имеются ли основания для постановки ПИД при выписке?
3. Нуждается ли пациент после выписки из стационара в
иммунологическом мониторинге?
104. Домашнее задание к занятию № 5
Повторение заданий к занятиям №1,№2,№3,№4.Занятие №5 –зачет 1 модуля.








































































































 medicine
medicine